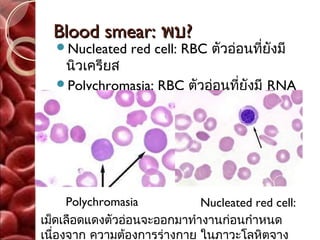
Blood smear: พบ?
  Nucleated    red cell: RBC ตัวอ่อนที่ยังมี
   นิวเครียส
  Polychromasia: RBC ตัวอ่อนที่ยังมี RNA
   ทำาให้ติดสีนำ้าเงินม่วง




     Polychromasia           Nucleated red cell:
เม็ดเลือดแดงตัวอ่อนจะออกมาทำางานก่อนกำาหนด
เนืองจาก ความต้องการร่างกาย ในภาวะโลหิตจาง
   ่

Recommended
PPT
TAEM10: Endocrine Emergency
PDF
SฺBAR เอสบา การสื่อสารอย่างปลอดภัย
PDF
PPT
การพยาบาลผู้ป่วยที่มีอารมณ์ผิดปกติ โดย อ.วิไลวรรณ บุญเรือง
PDF
PDF
การพยาบาลผู้ป่วยที่มีปัญหา ของระบบทางเดินหายใจ
PPTX
PDF
1.6.3 สารอาหารทางหลอดเลือดดำ
PDF
Orientation 551495 : Primary Medical Care
PDF
PDF
PDF
PDF
PDF
PDF
PDF
Case study : dengue fever
DOC
การวินิจฉัยชุมชน อ.สมเกียรติ
PDF
Ciprofloxacin hydochloride tablet n_due form1
PPT
PPT
PPTX
PDF
PDF
PDF
PDF
Total parenteral nutrition
PDF
การประเมินระบบกระดูก กล้ามเนื้อและข้อ
PDF
PPT
Cvp central venous pressure monitoring
PDF
PPT
More Related Content
PPT
TAEM10: Endocrine Emergency
PDF
SฺBAR เอสบา การสื่อสารอย่างปลอดภัย
PDF
PPT
การพยาบาลผู้ป่วยที่มีอารมณ์ผิดปกติ โดย อ.วิไลวรรณ บุญเรือง
PDF
PDF
การพยาบาลผู้ป่วยที่มีปัญหา ของระบบทางเดินหายใจ
PPTX
PDF
1.6.3 สารอาหารทางหลอดเลือดดำ
What's hot
PDF
Orientation 551495 : Primary Medical Care
PDF
PDF
PDF
PDF
PDF
PDF
PDF
Case study : dengue fever
DOC
การวินิจฉัยชุมชน อ.สมเกียรติ
PDF
Ciprofloxacin hydochloride tablet n_due form1
PPT
PPT
PPTX
PDF
PDF
PDF
PDF
Total parenteral nutrition
PDF
การประเมินระบบกระดูก กล้ามเนื้อและข้อ
PDF
PPT
Cvp central venous pressure monitoring
Similar to Hemolytic anemia
PDF
PPT
PPT
PPT
PPT
PDF
PDF
Clinical practice guideline_of_anemia(cpg)
PPT
งานให้ความรู้เรื่องThalของหมอนภมาศ
PPT
PDF
The Antiglobulin Test บรรยาย 6611038J4J9654321.pdf
PDF
PDF
PDF
PDF
โปรแกรมตรวจสุขภาพ 13 รายการ 999 บาท
KEY
PDF
PDF
PPT
Cp 50 10-18 4 talk lab - class slide ha
PDF
Compre step 2_2010 si key
PDF
Hemolytic anemia 1. Anemia
Hemolytic anemia
Auto Immune Hemolytic Anemia
(AIHA)
By Softmail
2. Definition
Anemia เป็นลักษณะอาการทางคลินิกของ
โรค(disease)
หมายถึง ภาวะ “ซีด” หรือ “โลหิตจาง”
Hemolysis หมายถึง แตกตัว-สลายตัว
Hemolytic anemia(HA) หมายถึง ภาวะโลหิต
จางที่เกิดจากการแตกสลาย มีทำาลาย เม็ดเลือดแดง
คือ ภาวะที่เม็ดเลือดแดงจะมีอายุสนลง
ั้
Autoimmune hemolytic anemia(AIHA)
คือ ภาวะที่เม็ดเลือดแดงจะมีอายุสนลง จากภูมิ
ั้
ต้านทานตนเอง
3. Hemolytic anemia เป็นสาเหตุ กลุ่ม
หนี่งของภาวะโลหิตจาง ที่มีสาเหตุอยู่
เป็นจำานวนมาก
AIHA เป็นโรคในกลุ่ม
hemolytic anemia Anemia
ซึ่งมีอยู่หลายโรคเช่นกัน
Hemolytic Anemia
AIHA เป็นส่วนหนึง
่
ของ HA และ AIHA
HA เป็นส่วนหนึ่ง
ของ Anemia
4. 5. Normal Red cells
ลักษณะ ค่อน
ข้างกลม
เว้าตรงกลาง
(biconcave disc
shape)
มีสีแดง
เนื่องจากมี ฮีโม
โกลบิน
มีอายุประมาณ
120 วัน
ถ่ายภาพด้วยเทคนิค Scanning Electron Microscope(SEM)
ในร่างกายจะมีเม็ดเลือดแดง ประมาณ 20-30 ล้านล้านเซลล์
ผูหญิง
้ 4-5 ล้านเซลล์ต่อไมโครลิตร
ผูชาย 5-6 ล้านเซลล์ต่อไมโครลิตร
้
6. Red blood cells: blood smear
ตรงกลาง1/3ซีด
เนื่องจากเป็น
รอยเว้า
ขนาด 7-8
ไมครอน
ไม่มีนิวเคลียส
ภายในเซลล์ K
สูง
ภายในมีสาร
สำาคัญ คือ
hemoglobin
ถ่ายภาพจากกล้องจุลทรรศ์ ย้อมด้วย hematoxylin and eosin (H&E)
ปริม าตร เม็ดเลือดแดงเฉลี่ยปกติ 83-97 fl = MCV (mean
corpuscular volume)
7. RBC: Hemoglobin (Hb)
ประกอบด้วย โปรตีน
4 globin chain+ heme
ค่า ปกติ
เพศชาย 13.8 – 17.2 g/dL
เพศหญิง 12.1 – 15.1 g/dL
heme = Fe + porphylin ring
•MCH(mean corpuscular hemoglobin)
ปริม าณ เฉลี่ยของฮีโมโกลบินในเม็ดเลือดแดงปกติ = 27-32 pg
•MCHC(mean corpuscular hemoglobin concentration)
ความเข้ม ข้น เฉลี่ย ของฮีโ มโกลบิน ในเม็ดเลือดแดงปกติ =
8. 9. Anemia
Hb/HCt < 80 % ของค่าเฉลี่ยมนุษย์ปกติ
HCt <33% ในสตรีวัยเจริญพันธุ์
HCt <36% ในผู้ชาย และ สตรีวัยหมดระดู
RBC indices
MCV (mean corpuscular volume)
ปริม าตร เม็ดเลือดแดงเฉลียปกติ = 80-96 fl
่
MCH(mean corpuscular hemoglobin)
ปริม าณ เฉลี่ยของฮีโมโกลบินในเม็ดเลือดแดงปกติ
= 27-32 pg
MCHC(mean corpuscular hemoglobin
concentration)
ความเข้ม ข้น เฉลี่ย ของฮีโ มโกลบิน ในเม็ดเลือด
แดงปกติ = 33-36 g/dl
RWD(red cell distribution width )
10. วงจรชีวิต Red blood cell
สร้า ง
ทำา ลาย(ต
(เกิด )
เรียน จดจำา ภูมิ าย)
ต้านทาน
ทำางาน ขนส่ง O2
ซ่อมแซม
เข้า สู่ร ะบบไหลเวีย น : อายุเ พีย ง 120
11. การวินิจฉัยภาวะ Anemia
แบ่ง 3 กลุมตามวงจงชีวิต
่
(pathophysiologic approach)
สร้างน้อย-เกิดน้อย Impaired RC formation
ปัญหาทีการสร้างเม็ดเลือดแดงผิดปกติ จาก
่
ไขกระดูก หรือ ขาดสารที่จำาเป็นในการ
สร้างเม็ดเลือดแดง
ทำาลาย-ตายมาก Hemolytic anemia
โครงสร้างเม็ดเลือดแดงผิดปกติ มีสารหรือ
ภูมิคุ้มกันทำาลายตนเอง ทำาให้มีการแตก
สลายตัวของเม็ดเลือด ถูกจับทำาลายได้
เสียเลือด สูญเสีย Blood loss
เลือดออกในระบบทางเดินอาหาร ทางเดิน
ปัสสาวะ สูญเสียเลือดโดยที่ร่างกายสร้าง
ใหม่ไม่ทน ั
12. Etiology classification : Anemia
Impaired RC B12,iron deficiency
formation Aplastic anemia
เกิดน้อย Neoplasm
Hemolytic Thalassemia
anemia AIHA
ตายมาก
Renal/GI loss
Blood loss
สูญเสีย
External cause: trauma
Etc.
13. Anemia approach
ประวัติ ตรวจร่างกาย ร่วมกับ ผลตรวจทาง
ห้องปฏิบัติการเบื้องต้น CBC, blood
smear, Reticulocyte count, Coomb’s test
ไขกระดูกทำางานผิดปกติ : ไข้ ก้อนตาม
ร่างกาย นำ้าหนักลด ปวดกระดูก เลือดออก
ผิดปกติ
ทำาลายมาก : ซีด เหลือง ตับม้ามโต
ปัสสาวะเข้ม ดำา
เสียเลือด : ถ่ายดำา อาเจียนเป็นเลือด การ
ผ่าตัด ระดูมาก
14. CBC: Complete blood count
Hemoglobin
Hematocrit
WBC count
Platelet count
Blood smear: RBC morphology,WBC
differentiation, platlet estimate
RBC index: MCV,MVH,MCHC
MCV ปริมาตรเม็ดเลือดแดง
15. Blood smear
ดูลักษณะของ RBC ได้แก่ ขนาด รูปร่าง การ
ย้อมติดสี การจับกลุม
่
เป็นต้น สามารถบอกสาเหตุของภาวะซีดได้
ตัวอย่างเข่น
Macrocyte(MCV>100): cirrhosis, vitB12
deficiency etc.
Microcyte(MCV<80):iron def., thalassemia
etc.
Spherocyte เม็ดเลือดแดงทรงกลมป่องออก:
heriditary spherocystosis เป็นต้น
Reticulocyte: RBC ตัวอ่อนติดสีเป็นจุดๆ
Etc.
16. Reticulocyte
Reticulocyte count: เพิ่มขึ้น
Reticulocyte count = immature RBC
ปกติอยู่ใน bone marrow จะไม่ออกมา
เม็ดเลือดแดงตัวอ่อนจะออกมาทำางานก่อน
กำาหนดเนืองจากร่างกายต้องการ เม็ดเลือด
่
แดงเพิ่มขึ้น จากภาวะโลหิตจาง ที่
ไขกระดูกยังทำางานได้ดี
17. Coomb’s test(กรณีสงสัย AIHA)
เป็นการทดสอบหา antibody ที่มีต่อ antigen
บนผิวเม็ดเลือดแดง
Antibody คือ โปรตีนของระบบภูมิคุ้มกันที่
มีหน้าที่จับและทำาลายสิ่งแปลกปลอมที่เข้าสู่
ร่างกาย
Antibody มีหลายชนิด ซึ่งจะจดจำาเป้า
หมายที่จำาเพาะ คือ antigen ซึ่งมีหลาก
หลายตามแต่ชนิดของสิ่งแปลกปลอมนั้น
Antigen สารที่สามารถ กระตุ้นระบบภูมิ
ต้านทานแบบจำาเพาะได้
18. 19. 20. 21. 22. 23. Acquired
Immune
-Autoantibody: AIHA
-Alloantibody: transfusion reaction etc.
-Drug-induced: quinidine, isoniazid, etc.
Non-immune
-Paroxysmal Nocturnal hemoglobinuria
เม็ดเลือดแดงแตกขณะหลับ ตื่นเช้า ปัสสาวะสี
แดง-โคลา
-Drug,venom, toxin
-Organ disfunction
-Machanical trauma
-Infection
-disease อื่นๆ leukemia, SLE, infectious
mononucleosis
24. Hemolytic anemia : อาการและ
อาการแสดง
ซีด เหลือง อ่อนเพลีย ไม่มีแรง มีไข้ วิง
เวียน มึนงง หัวใจเต้นเร็ว
Acute intravascular hemolysis
hemoglobinemia, hemoglobinuria ปัสสาวะ
สีชา หรือ โคลา ถ้ารุนแรง shock, DIC,
renal failure เสียชีวิต
Chronic hemolysis เกิดตับม้ามโต กระดูก
เปลี่ยนรูปร่าง เหล็กเกิน เป็นนิ่ว เสียชีวิต
จาก congestive heart failure
25. 26. ตัว อย่า ง
Thalassemia: ซีด เหลือง ตับ
ม้ามโต Mongoloid-face มีประวัติ
ครอบครัว
(chronic extravascular hemolytic anemia จะ
มีอาการ ซีด+เหลือง+ตับม้ามโต)
CBC: MCVตำ่าหรือปกติ, RDW
สูงขึ้น, reti-count สูง
Blood smear: hypochromic,
microcytic, anisocytosis,
poikilocytosis and target cell
เป็นต้น
Comfirm: Hb typing
27. ตัวอย่าง
G6PD deficiency
Acute hemolytic anemia: ซีด เหลือง ตับ
ม้ามไม่โต ปัสสาวะสีดำา เป็นมาไม่กี่วัน
(intravascular hemolysis ตับม้ามไม่โต)
เป็นหลังใช้ยา เพศชาย มักมีประวัติตั้งแต่
เด็ก
Confirm:ระดับ enzyme G6PD
28. ตัว อย่า ง
AIHA : ซีด+เหลือง+ตับม้ามโต เป็นacute
หรือ subacute ก็ได้
CBC: MCVปกติ, reti-count สูง, RDW
ปกติ
Confirm: direct Coomb’s test
หา autoantibody บนผิว RBC
ผล Positive คือเม็ดเลือดเกาะกลุ่ม
ผล Negativeคือเม็ดเลือดไม่เกาะกัน
29. ตัวอย่าง
PNH(Paroxymal hemoglobinuria)
Clinical :ซีด ไม่เหลือง ปัสสาวะสีเข้ม แดง
ดำาโคล่า เป็นตอนเช้าตื่นนอน ตับม้ามไม่โต
ปัสสาวะสีเข้ม
แดง ดำาโคล่า
Confirm: Ham’s test ทดสอบการแตกตัว
ของเม็ดเลือดแดงเมื่อถูกทำาให้เป็นกรด ที่
pH ประมาณ 6.2
หลอดที่ 2,4 ผู้ป่วย serum
กลายเป็นสีแดง
หลอดที่ 1,3 คนปกติ
30. 31. 32. Classification of AIHA
แบ่งได้ 2 ชนิด ตามคุณสมบัติของ
autoantibody
คือ ตามอุณหภูมิที่ antibody(Ab) จับกับ
Antigen(Ag)
1. Warm type จับได้ดีที่ T 37˚C
2. Cold type จับได้ดีที่ T< 37˚C
มักตำ่ากว่า 30˚C
33. Warm-reacting antibody type
เป็น AIHA ที่ autoantibody(Ab) จับกับ
Antigen(Ag) บนผิวเม็ดเลือดแดง ได้ดีที่ T
37˚C
พบได้ 80 % ของ AIHA
RBC มักถูก macrophage จับทำาลายนอก
หลอดเลือด
(ม้ามมักจะโต)
มักไม่ทำาให้เกิด autoagglutination หรือ
intravacular hemolysis
มักมาด้วยอาการ ซีด เหลือง ตับ ม้ามโต
34. Cold-reacting antibody type
เป็น AIHA ที่ autoantibody(Ab) จับกับ
Antigen(Ag) บนผิวเม็ดเลือดแดง ได้ดีที่ T
< 37˚C
ส่วนใหญ่ดีที่สุดที่ T 4˚C
พบได้ 20 % ของ AIHA
RBC มักถูก antibody จับและกระตุ้นระบบ
complement ตลอดกระบวนการ เป็นผลให้
เม็ดเลือดแดงแตกในกระแสเลือด
มักทำาให้เกิด autoagglutination หรือ
intravacular hemolysis (ม้ามไม่โต)
มักมาด้วยอาการซีด เหลือง ปัสสาวะเข้ม สี
โคล่า
35. 36. อาการและอาการแสดง
อาการโลหิตจาง : ซีด เพลีย วิงเวียน
เหนือยง่าย หากรุนแรงมากเกิด congestive
่
heart failure ได้
บางรายเหลือง ปัสสาวะเข้ม อาจมีไข้ตำ่าๆ
ตรวจร่างกาย
ซีด เหลือง ตับม้ามโต(50% ของผู้ปวย) ่
37. 38. Laboratory
CBC: HB,Hct ตำ่า WBC,Platelet ปกติ
Blood smear: polychromasia, nucleated
red cell, spherocytes เพิ่มขึ้น
บางรายพบ autoagglutinationได้
Reticulocyte count: เพิ่มขึ้น
Autoagglutination= การจับกลุมของ RBC
่
Reticulocyte count = immature RBC ปกติ
อยู่ใน bone marrow จะไม่ออกมา
39. Blood smear: พบ?
Nucleated red cell: RBC ตัวอ่อนที่ยังมี
นิวเครียส
Polychromasia: RBC ตัวอ่อนที่ยังมี RNA
ทำาให้ติดสีนำ้าเงินม่วง
Polychromasia Nucleated red cell:
เม็ดเลือดแดงตัวอ่อนจะออกมาทำางานก่อนกำาหนด
เนืองจาก ความต้องการร่างกาย ในภาวะโลหิตจาง
่
40. Blood smear: พบ?
spherocytes เพิ่มขึ้น
เม็ดเลือดแดงเป็นทรงกลม
RBC ผิดปกติ RBC ปกติ
spherocyte Biconcave
ไม่เว้า ตรง
กลาง
Blood smear
RBC กลมตรง
กลางไม่ซีด
41. Blood smear: พบ?
บางรายพบ autoagglutinationได
คือ RBC จับกัน
เป็นกลุ่ม
เนืองจาก
่ antibody จับ antigen บนผิว RBC
ทำาให้RBC ติดกันเป็นกลุ่ม
42. Reticulocyte count
Reticulocyte count = immature RBC
Reticulocyte count(RC) : เพิ่มขึ้น ใน
AIHA
ปกติ reticulocyte อยู่ใน bone marrow จะ
ไม่ออกมา แต่ต้องออกมาทำางานก่อน
(ถ้าซีดจาก ไขกระดูก ผิองจากร่างกายต้องการ เม็ดเลือด
กำาหนดเนื่ ดปกติ RC จะตำ่า)
แดงเพิ่มขึ้น จากภาวะโลหิตจาง
43. Serology *****
เป็นหัวใจของการวินิจฉัยโรค
AIHA
หาหลักฐานของ autoantibody ต่อ
มี
เม็ดเลือดแดง
3 วิธีการทีใช้บ่อย
่
1) Saline agglutination test
2) Direct agglutination test หรือ
direct Coombs’ test
หา Ab บนเม็ดเลือดแดง
3) Indirect agglutination test หรือ
indirect Coombs’ test
หา autoantibody อิสระใน serum
44. Saline agglutination test
ทำาง่าย ทำาได้ข้างเตียง
นำ้าเกลือ(NSS) 1 หยด ผสม เลือด 1 หยด ดู
ด้วยกล้องจุลทรรศน์ ดูการจับกลุ่มของเม็ด
เลือดแดง
หากพบอาจช่วยการวินิจฉัย AIHA ได้
45. Direct agglutination test หรือ
direct Coombs’ test
เป็นวิธีการหา หา autoantibody บนเม็ด
เลือดแดง ที่เป็นชนิด incomplete antibody
โดยใช้ antiglobulin antibody เป็นตัวเชือม
่
ให้เกิดการ agglutination
ใช้ วินิจฉัย AIHA antibody
antiglobulin
autoantibody บนเม็ดเลือดแดง ด warm-type
ชนิ
46. 47.